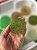
Sabonete corporal - Imagem 2

Natureza em barra para cuidar do corpo e renovar as energias!
Limpeza suave, aroma acolhedor, cada versão foi pensada para atender um momento do seu dia, seja relaxar, energizar ou simplesmente se reconectar com o cuidado do corpo.
Camomila- calmante e delicada, ideal para peles sensíveis e momento de relaxamento.
Erva doce- refrescante e suave, com efeito purificante e aroma leve que acalma.
Alecrim- estimulante e revigorante, ótimo para começar o dia com energia e clareza.
Arruda com sal grosso- um verdadeiro banho para renovar as energias.
Contém 80gr
Composição: glicerina, extrato glicerinado, essência, lauril, erva.
*pode haver alteração de cor
Produtos relacionados
A Encanto do Cheiro nasceu em 2019 por Rafaela Maia com um propósito claro: trazer para você soluções que não apenas cuidam da sua pele, mas também nutrem a sua alma, Acreditamos que cuidar de si mesma não é apenas uma rotina, mas sim um ritual sagrado de amor-próprio. Nossa missão vai além de apenas fornecer produtos; buscamos elevar a sua autoestima e despertar a sua confiança interior, para que você possa enfrentar cada dia com beleza, força e uma sensação renovada de encanto.